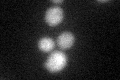
YGL160W
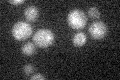
YGL160W

View description
Putative protein of with similarity to iron/copper reductases (FRE1-8), possibly involved in iron homeostasis; may interact with ribosomes; null mutant displays elevated frequency of mitochondrial genome loss
Localization:
Intensity:
Fold change:
Significance:
-
C’ GFP library in SD

cytosol20.18 -
N' NOP1pr-GFP in SD

ER44.9764 -
N' TEF2pr-mCherry in SD

ER35.7737 -
N' NATIVEpr-GFP in SD

below threshold19.6581 -
N' TEF2pr-VC and Cyto-VN in SD

below threshold23.7974 -
C’ GFP library in SD+DTT
cytosol19.510.96No -
C’ GFP library in SD+H2O2

cytosol20.160.99No -
C’ GFP library in Starvation Media
cytosol18.270.9No -
C’ GFP library on the background of Pup2-DaMP

cytosol -
C’ GFP library on the background of CCT mutant

cytosol22.86151.13271No
